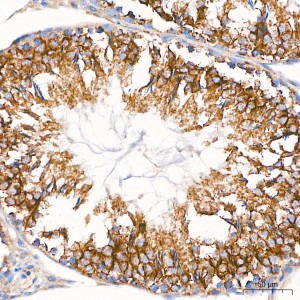
KD-Validated VDAC3 Rabbit mAb (20 μl)

| Reactivity: | Human, Mouse, Rat |
| Applications: | WB, IHC, IF/IC, ELISA |
| Host Species: | Rabbit |
| Isotype: | IgG |
| Clonality: | Monoclonal antibody |
| Gene Name: | voltage dependent anion channel 3 |
| Gene Symbol: | VDAC3 |
| Synonyms: | VDAC-3; HD-VDAC3 |
| Gene ID: | 7419 |
| UniProt ID: | Q9Y277 |
| Immunogen: | A synthetic peptide corresponding to a sequence within amino acids 1-100 of human VDAC3 (NP_005653.3). |
| Dilution: | WB 1:500-1:1000; IHC 1:50-1:200; IF/IC 1:50-1:200 |
| Purification Method: | Affinity purification |
| Concentration: | 1.68 mg/ml |
| Buffer: | PBS with 0.09% Sodium azide, 0.05% BSA, 50% glycerol, pH7.3. |
| Storage: | Store at -20°C. Avoid freeze / thaw cycles. |
| Documents: | Manual-VDAC3 monoclonal antibody |
Background
This gene encodes a voltage-dependent anion channel (VDAC), and belongs to the mitochondrial porin family. VDACs are small, integral membrane proteins that traverse the outer mitochondrial membrane and conduct ATP and other small metabolites. They are known to bind several kinases of intermediary metabolism, thought to be involved in translocation of adenine nucleotides, and are hypothesized to form part of the mitochondrial permeability transition pore, which results in the release of cytochrome c at the onset of apoptotic cell death. Alternatively transcript variants encoding different isoforms have been described for this gene.
Images
 | Western blot analysis of various lysates using [KD Validated] VDAC3 Rabbit mAb (A26244) at 1:1000 dilution incubated overnight at 4℃. Secondary antibody: HRP-conjugated Goat anti-Rabbit IgG (H+L) (AS014) at 1:10000 dilution. Lysates/proteins: 25 μg per lane. Blocking buffer: 3% nonfat dry milk in TBST. Detection: ECL Basic Kit (RM00020). Exposure time: 20s. |
 | Western blot analysis of lysates from wild type (WT) and VDAC3 knockdown (KD) 293T cells using [KD Validated] VDAC3 Rabbit mAb (A26244) at 1:1000 dilution incubated overnight at 4℃. Secondary antibody: HRP-conjugated Goat anti-Rabbit IgG (H+L) (AS014) at 1:10000 dilution. Lysates/proteins: 25 μg per lane. Blocking buffer: 3% nonfat dry milk in TBST. Detection: ECL Basic Kit (RM00020). Exposure time: 20s. |
 | Western blot analysis of lysates from Rat testis using [KD Validated] VDAC3 Rabbit mAb (A26244) at 1:1000 dilution incubated overnight at 4℃. Secondary antibody: HRP-conjugated Goat anti-Rabbit IgG (H+L) (AS014) at 1:10000 dilution. Lysates/proteins: 25 μg per lane. Blocking buffer: 3% nonfat dry milk in TBST. Detection: ECL Basic Kit (RM00020). Exposure time: 15s. |
 | Immunohistochemistry analysis of paraffin-embedded Rat testis tissue using [KD Validated] VDAC3 Rabbit mAb (A26244) at a dilution of 1:200 (40x lens). High pressure antigen retrieval performed with 0.01M Citrate Buffer(pH 6.0) prior to IHC staining. |
 | Immunohistochemistry analysis of paraffin-embedded Rat kidney tissue using [KD Validated] VDAC3 Rabbit mAb (A26244) at a dilution of 1:200 (40x lens). High pressure antigen retrieval performed with 0.01M Citrate Buffer(pH 6.0) prior to IHC staining. |
 | Confocal imaging of paraffin-embedded Mouse testis tissue using [KD Validated] VDAC3 Rabbit mAb (A26244, dilution 1:200) followed by a further incubation with Cy3 Goat Anti-Rabbit IgG (H+L) (AS007, dilution 1:500) (Red). DAPI was used for nuclear staining (Blue). High pressure antigen retrieval performed with 0.01M Citrate Buffer(pH 6.0) prior to IF staining. Objective: 40x. |
 | Confocal imaging of paraffin-embedded Rat testis tissue using [KD Validated] VDAC3 Rabbit mAb (A26244, dilution 1:200) followed by a further incubation with Cy3 Goat Anti-Rabbit IgG (H+L) (AS007, dilution 1:500) (Red). DAPI was used for nuclear staining (Blue). High pressure antigen retrieval performed with 0.01M Citrate Buffer(pH 6.0) prior to IF staining. Objective: 40x. |
 | Confocal imaging of 293T cells using [KD Validated] VDAC3 Rabbit mAb (A26244, dilution 1:200) followed by a further incubation with Cy3 Goat Anti-Rabbit IgG (H+L) (AS007, dilution 1:500) (Red). DAPI was used for nuclear staining (Blue). Objective: 100x. |
You may also be interested in: